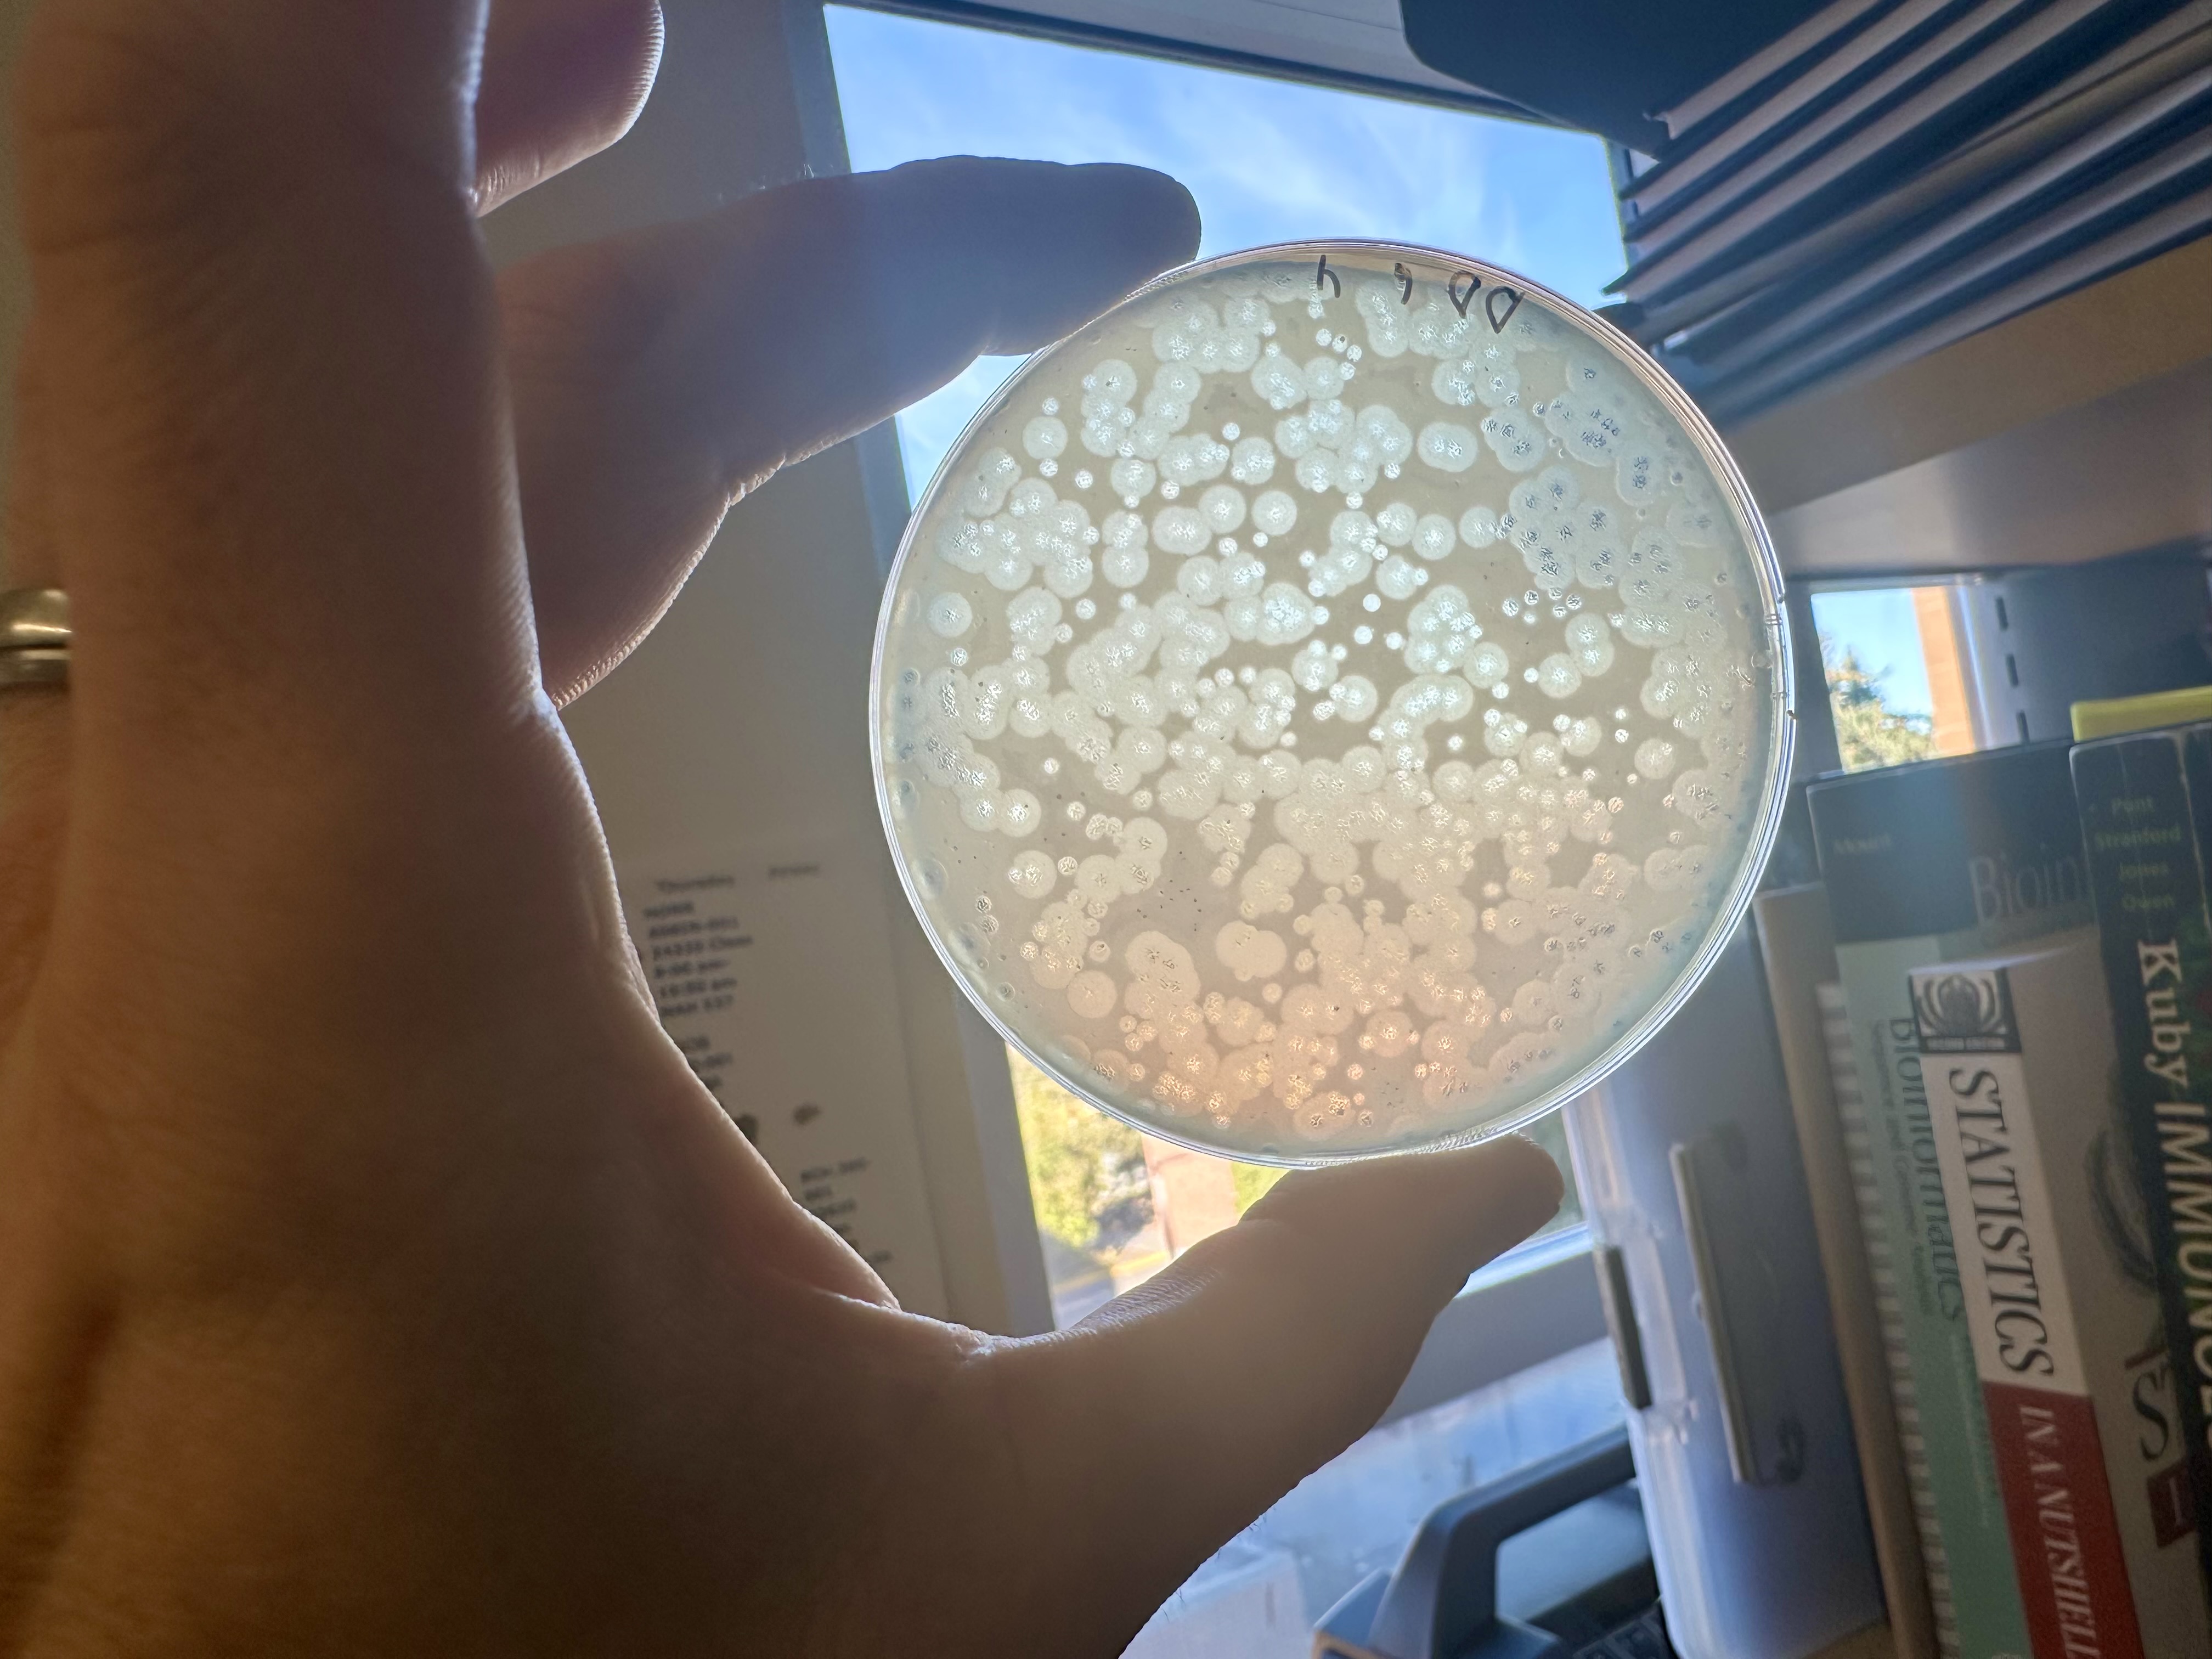
Lab bench with cultures and tools

Microscopy
Click to view photos

Microscopy
Click to view photos












Tick Pics
Click to view photos

Tick Pics
Click to view photos









Life at the Bench
Click to view photos

Life at the Bench
Click to view photos

Outdoor Life
Click to view photos

Outdoor Life
Click to view photos







